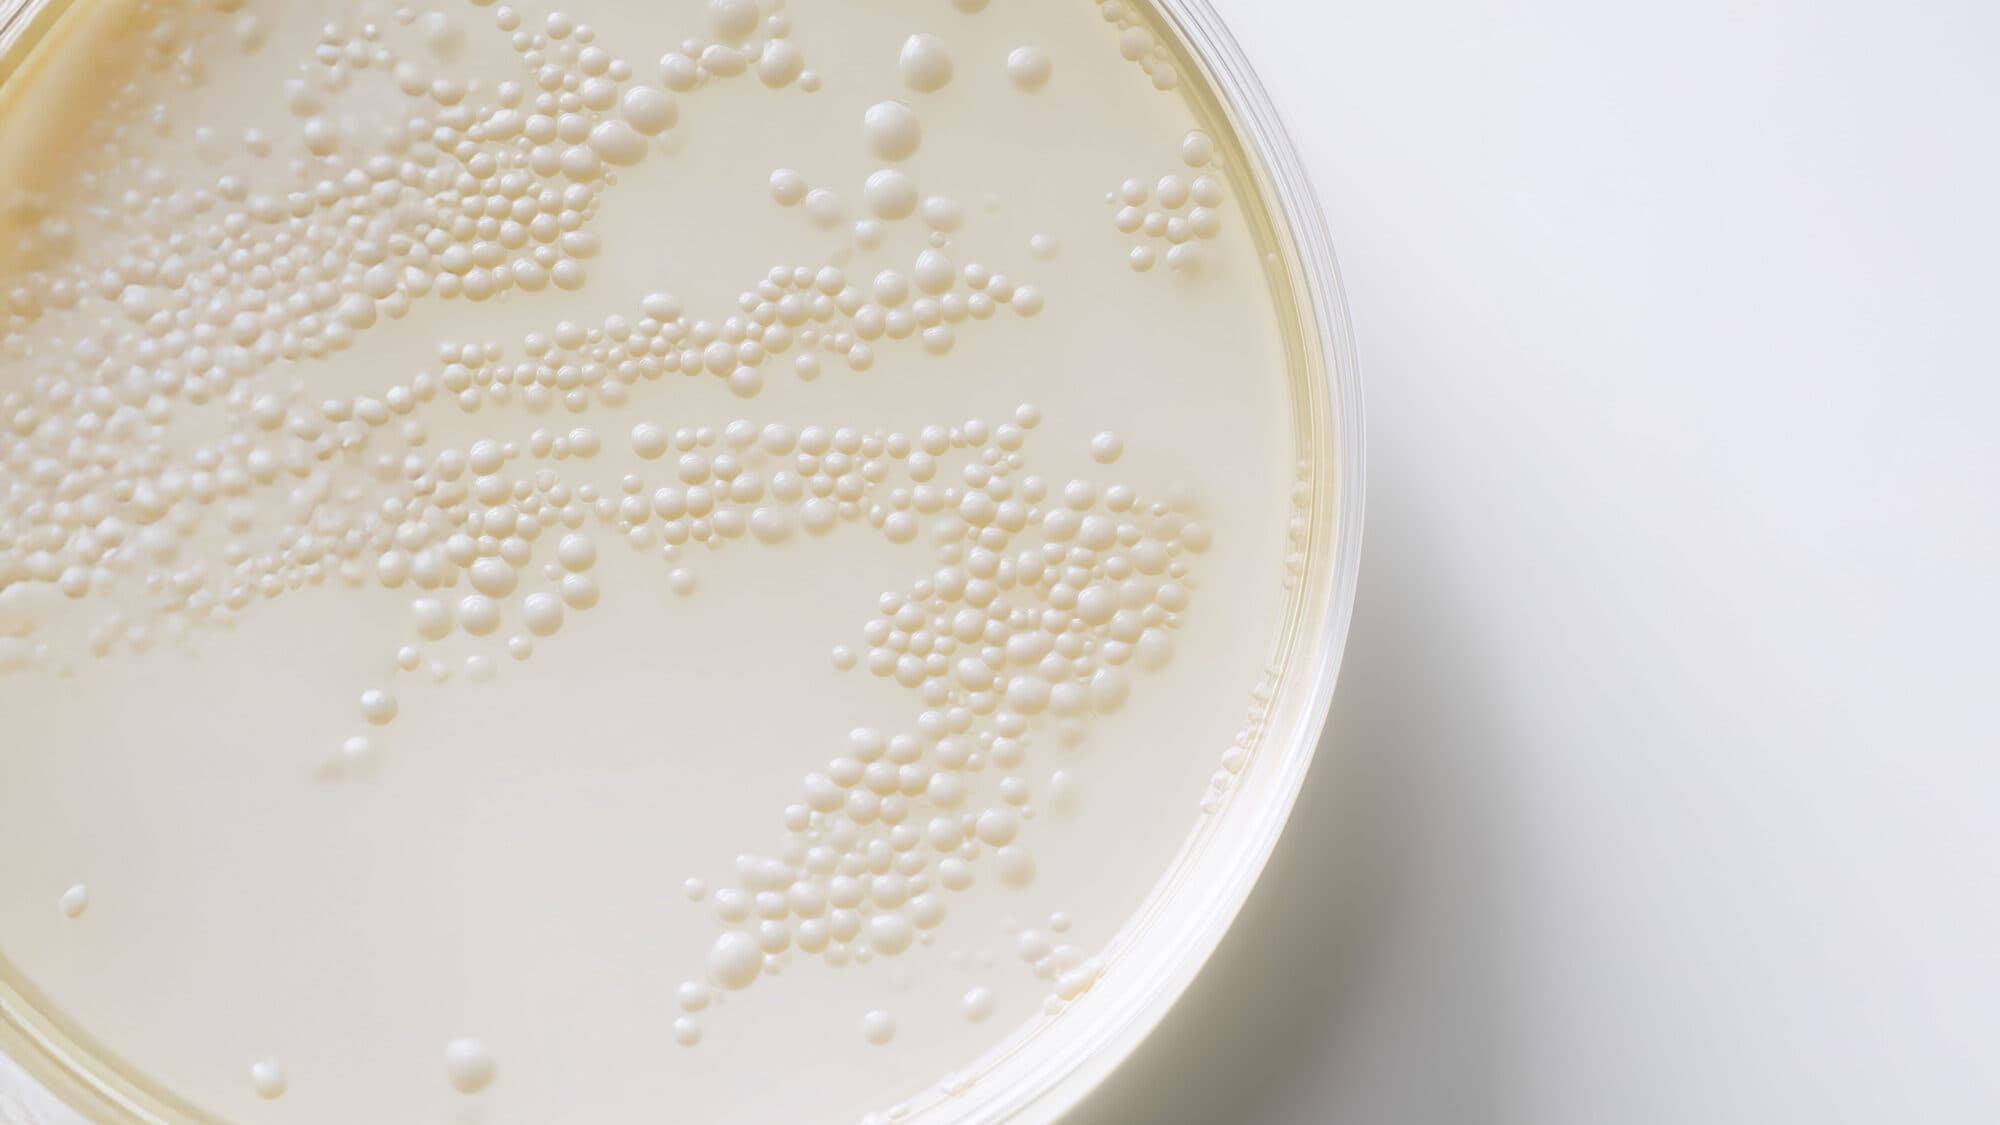
Petrischale mit gelblicher Flüssigkeit, KI-generiert

Neue Studien zu Darmbakterien: Schlüsselrolle bei Immunabwehr und Stoffwechsel
In den letzten Jahren hat sich das Mikrobiom zu einem der spannendsten Forschungsfelder der modernen Medizin entwickelt. Immer mehr Studien zeigen, dass die Darmflora nicht nur bei der Verdauung eine Rolle spielt, sondern auch entscheidend für Immunabwehr, Stoffwechsel und Blutzuckerkontrolle ist. Unser Darm ist nicht nur ein Organ für Nährstoffaufnahme – er ist ein hochkomplexes Kommunikationszentrum, das unser gesamtes Gesundheitssystem beeinflusst.
Mikrobiom & Immunabwehr – das Schutzschild im Darm
Rund 70 % unseres Immunsystems sitzt im Darm. Das Mikrobiom übernimmt dabei gleich mehrere Aufgaben:
- Es trainiert das Immunsystem, zwischen „Freund“ und „Feind“ zu unterscheiden.
- Bestimmte Bakterienarten wie Bacteroides fragilis fördern die Bildung von regulatorischen T-Zellen, die Entzündungen im Zaum halten.
- Eine vielfältige Darmflora verhindert überschießende Reaktionen – wie sie bei Allergien oder Autoimmunerkrankungen vorkommen.
- Durch die Produktion von kurzkettigen Fettsäuren (z. B. Butyrat) werden entzündungshemmende Prozesse angestoßen, die den Körper langfristig schützen.
Eine instabile Darmflora kann dagegen das Gegenteil bewirken: häufige Infekte, chronische Entzündungen oder sogar die Entstehung von Autoimmunerkrankungen.
Mikrobiom & Stoffwechsel – Balance für Energie und Gewicht
Das Mikrobiom beeinflusst direkt, wie wir Nährstoffe aufnehmen, speichern und verwerten:
- Blutzuckerregulation: Ein ausgewogenes Mikrobiom verhindert starke Blutzuckerschwankungen und sorgt für einen stabilen Energiehaushalt.
- Fettstoffwechsel: Dysbiose fördert Übergewicht, Fettleber und Insulinresistenz.
- Insulinsensitivität: Ein vielfältiges Mikrobiom verbessert die Aufnahmefähigkeit der Zellen für Insulin – ein Schlüsselfaktor zur Vorbeugung von Typ-2-Diabetes.
Interessanterweise zeigen Studien, dass zwei Menschen mit identischem Essen sehr unterschiedliche Blutzuckerreaktionen haben können – abhängig von der Zusammensetzung ihrer Darmflora.
Forschung & Studienlage – was die Wissenschaft aktuell zeigt
- Nature Medicine (2022): Bestimmte Mikrobiomprofile können individuelle Blutzuckerreaktionen nach Mahlzeiten vorhersagen.
- Cell (2023): Nach Antibiotikatherapie kann die Gabe gezielter Probiotika das Immunsystem deutlich schneller regenerieren.
- Science Translational Medicine: Mikrobiom-Interventionen könnten in Zukunft so individuell dosiert werden wie Medikamente – maßgeschneidert auf die persönliche Zusammensetzung der Darmflora.
Diese Erkenntnisse unterstreichen: Das Mikrobiom ist kein Nebenaspekt, sondern ein Schlüsselfaktor für Prävention und Therapie.
5 Wege, das Immunsystem über den Darm zu stärken
Health Standard Solutions – Unser Ansatz
Wir verbinden modernste Mikrobiom-Analysen mit wissenschaftlich fundierten Supplementen, die exakt auf die Bedürfnisse des Darms abgestimmt sind. Unsere Diagnostik zeigt, ob Ihr Mikrobiom ausreichend entzündungshemmende, immunmodulierende oder stoffwechselaktive Bakterien enthält – und wo Nachjustierung sinnvoll ist.

Fazit
Neue Studien machen klar: Das Mikrobiom ist ein Schlüsselorgan für Immunabwehr und Stoffwechsel. Eine gezielte Stärkung der Darmflora kann helfen, Abwehrkräfte zu verbessern, den Blutzucker stabil zu halten und das Risiko für chronische Erkrankungen zu senken. Wer heute in sein Mikrobiom investiert, baut den Grundstein für langfristige Gesundheit, Energie und Prävention.
